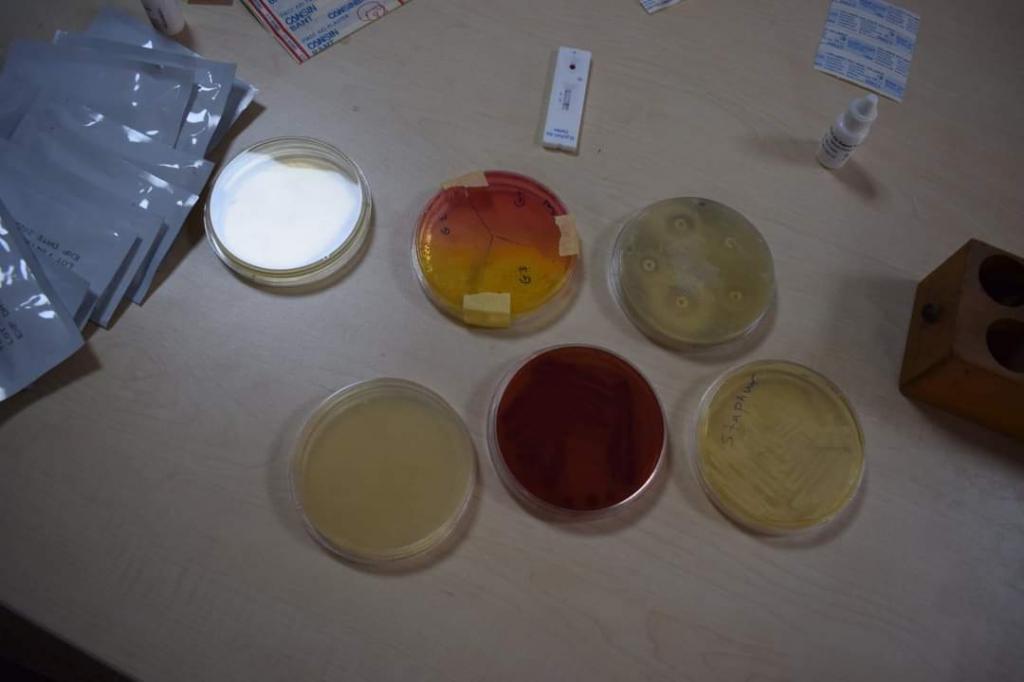

30 نوفمبر، 2021
استمرار الدورة العلمية التخصصية في فرع العلوم المختبرية السريرية

تستمر فعاليات الدورة العلمية التخصصية التي يقيمها فرع العلوم المختبرية السريرية و الموسومة”تحديات الاصابات الجرثومية الانتهازية” لليوم الثالث على التوالي حيث تضمن جدول أعمال اليوم الثالث في الدورة مجموعة من المحاضرات العلمية حول انواع الاصابات الجرثومية الانتهازية والفحوصات المختبرية اللازمة لتشخيصها، تلى ذلك فترة تدريب عملي على أساليب عزل للميكروبات المسببة للعدوى الانتهازية والتعامل معها.